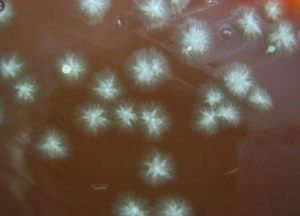
<p>“feet” </p>
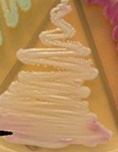
knowt flashcard image
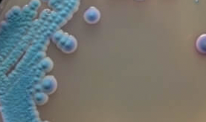
<p></p>
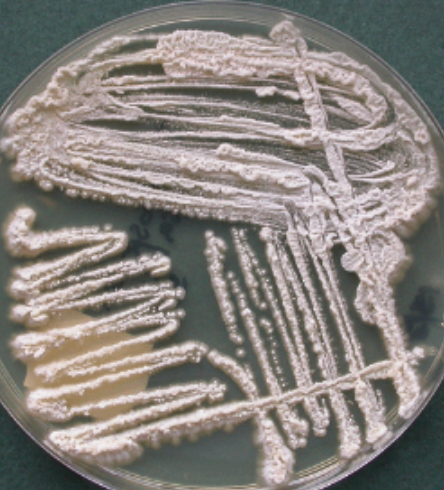
<p>causes white piedra</p>
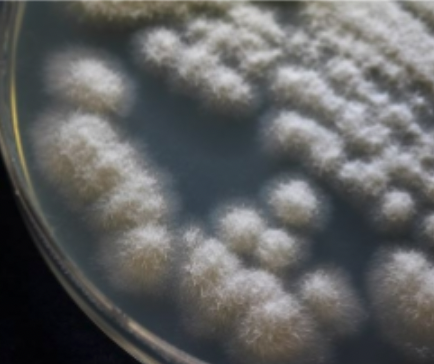
knowt flashcard image

Yeasts
0.0(0)
Studied by 2 peopleCard Sorting
1/14
There's no tags or description
Looks like no tags are added yet.
Last updated 3:21 PM on 4/2/26
Name | Mastery | Learn | Test | Matching | Spaced | Call with Kai |
|---|
No analytics yet
Send a link to your students to track their progress
15 Terms
1
New cards
Candida albicans microscopic
“terminal chlamydospores” in cornmeal

2
New cards
Candida albicans macroscopic
“feet”
3
New cards
Candida glabrata microscopic

4
New cards
Candida glabrata macroscopic
5
New cards
Candida tropicalis macroscopic
6
New cards
Candida tropicalis microscopic
pseudohyphae present

7
New cards
Candida parapsilosis microscopic

8
New cards
Candida parapsilosis macroscopic

9
New cards
Candida krusei microscopic
“cross-matchstick”

10
New cards
Cryptococcus neoformans microscopic

11
New cards
Cryptococcus gattii

12
New cards
Trichosporon beigelii macroscopic
causes white piedra
13
New cards
Trichosporon beigelii microscopic

14
New cards
Geotrichum macroscopic
15
New cards
Geotrichum microscopic

Explore top notes
Biology 120 Notes (Part 9) Phospholipids, Plasma Membrane, Diffusion, and Osmosis
Updated 1297d ago0.0(0)
Biology 120 Notes (Part 9) Phospholipids, Plasma Membrane, Diffusion, and Osmosis
Updated 1297d ago0.0(0)